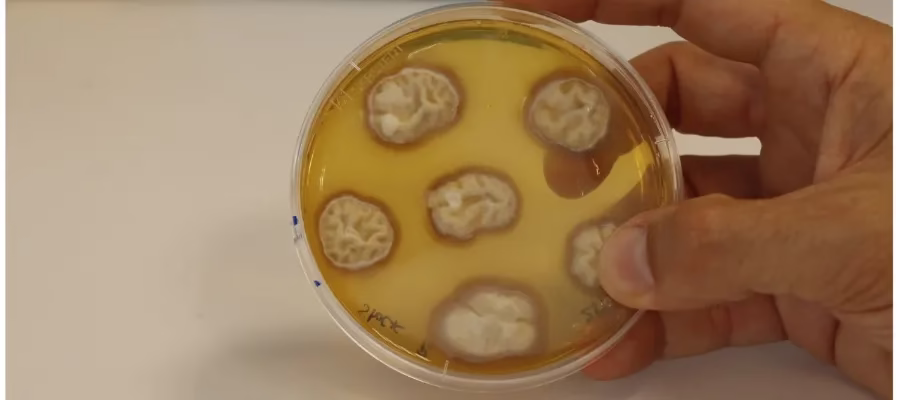

Forskare vid IHSM La Mayora i Algarrobo har identifierat mekanismen ”RALF22” som växter använder för att mer effektivt utnyttja näringsämnen.
Forskarna Javier Pozueta och Rafael Morcillo säger i ett uttalande att upptäckten har enorm potential för att utforma metoder för att göra växter mer toleranta mot torka, det gäller inte minst tomater.

Svenska Magasinet har tidigare berättat om forskningsinstitutet IHSM La Mayora i Algarrobo på östra Costa del Sol.
Läs mer: IHSM La Mayora startade 1961 – här vidgas kunskapens gränser
Det som började som ett spansk-tyskt internationellt samarbetsprojekt för mer än sex decennier sedan och har blivit ett stort internationellt referenscentrum inom jordbruksforskning, avgörande för utvecklingen av den blomstrande sektorn för subtropiska grödor i södra Spanien.
Den senaste upptäckten har publicerats i den vetenskapliga tidskriften Plant Physiology av flera forskare verksamma vid IHSM La Mayora.
Det i år presenterade forskare vid IHSM La Mayora en annan upptäckt där en genetisk kod i en bakterie kan eliminera svampar och parasiter i olika grödor. Det kan garantera garanterar överlevnaden av sojabönor- och melonplantager och bidra till större tillväxt och produktion.